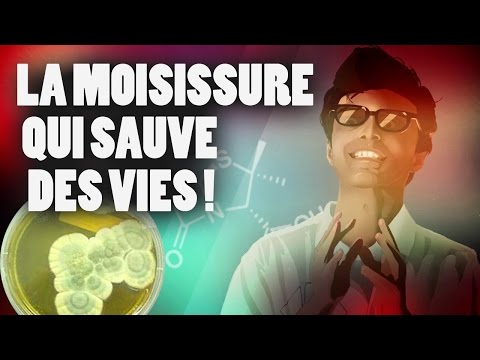

- Оригинальный выпуск
- Предыдущая серия S05E24 - QUI A LE PLUS GRAND SPERMATOZOÏDE ?
- Номер S05E25
- Страна Соединенные Штаты
-
Внешние ссылки
Страница на YouTube
-
Последнее обновление
26 mars 2026 - 10:08
на 11 базах данных
LA MOISISSURE QUI SAUVE DES VIES !
N'oubliez pas le petit pouce en l'air, très important :o
Tu peux cliquer ici pour t'abonner, love ▶ http://bit.ly/1LaNlBD
Ou trouver la chaîne :
Free : 207
Orange : 128
SFR : 206
Bouygues : 212
CanalSat : 90
Numéricable : 146
@ScienceetvieTV
https://www.facebook.com/ScienceetvieTV
https://twitter.com/ScienceetvieTV
https://www.youtube.com/user/encyclopedia
Le Tipeee : https://www.tipeee.com/dr-nozman
Twitter : https://twitter.com/DrNozman
Facebook : http://on.fb.me/1qEkh9H
Instagram : https://instagram.com/docnozman/
https://www.instagram.com/nozmacro/
Snapchat : Drnozman
A très bientôt pour la prochaine vidéo !